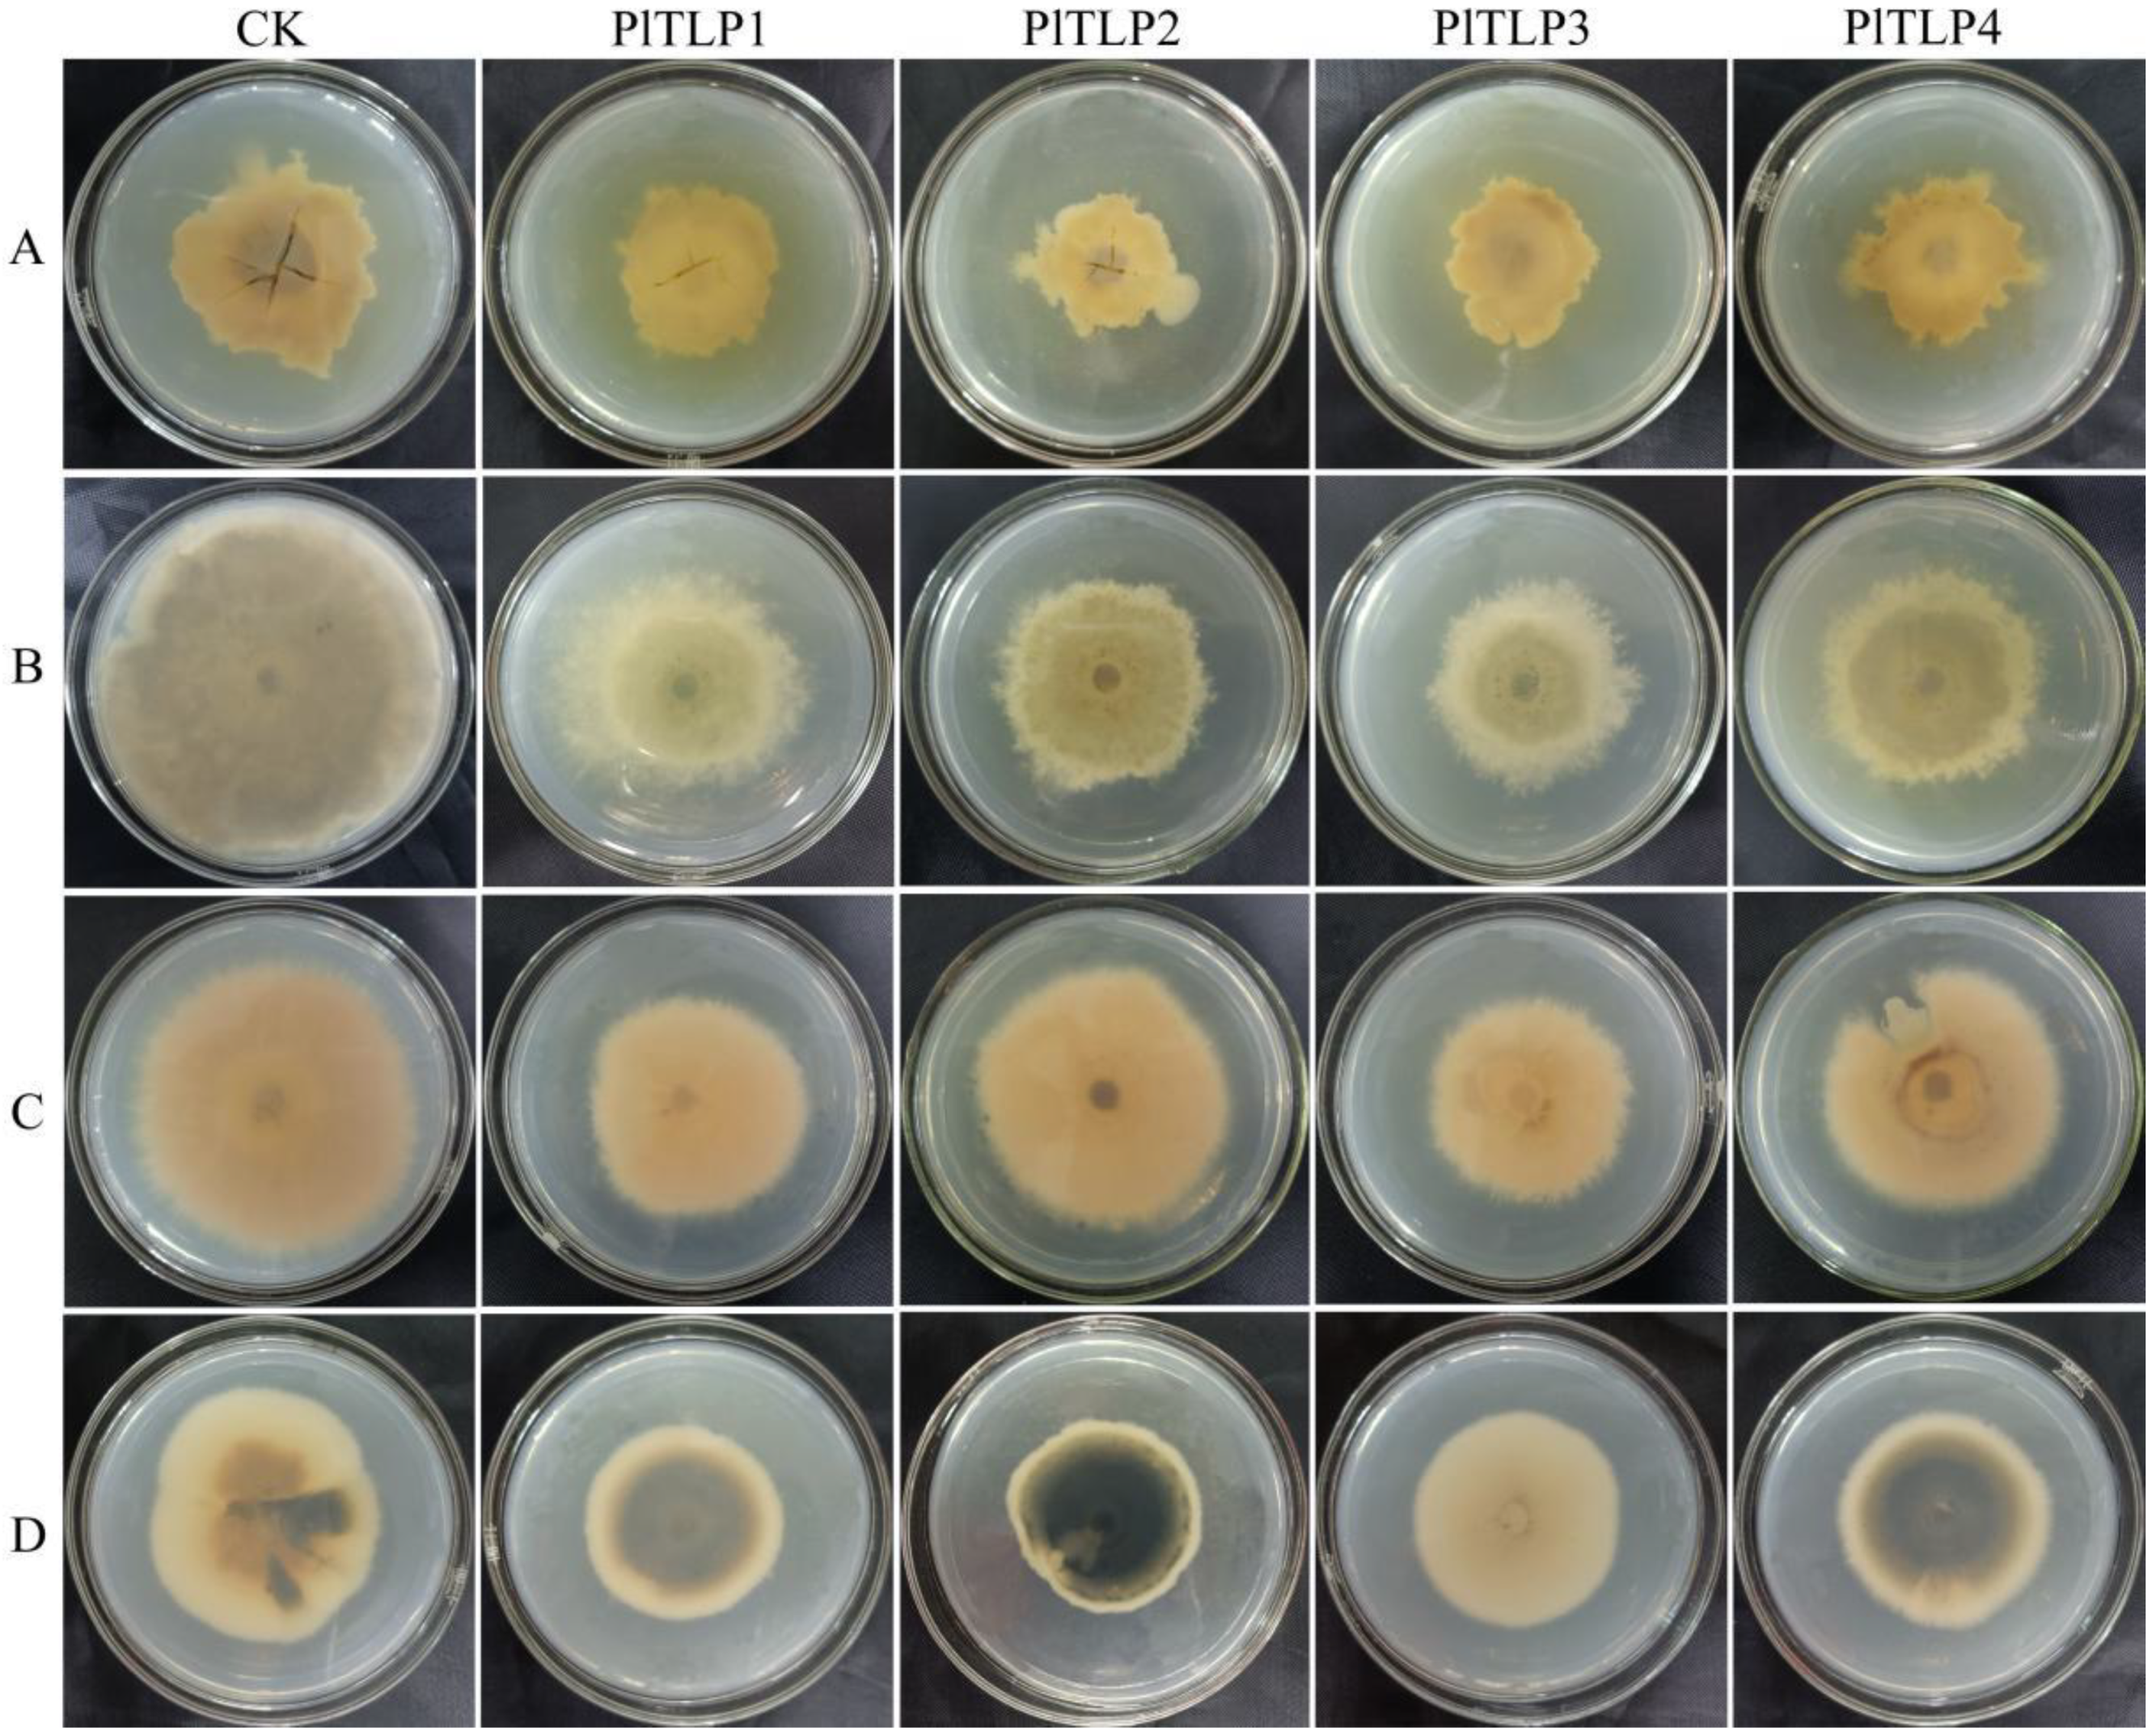
Forests 12 01268 g006

Molecular Identification and Antifungal Properties of Four Thaumatin-like Proteins in Spruce (Picea likiangensis)
Abstract
:1. Introduction
2. Materials and Methods
2.1. Plant Materials, Plasmids and Strains
2.2. Total RNA Extraction and cDNA Synthesis
2.3. PCR Amplification
2.4. Sequence Analysis
2.5. qPCR Analysis
2.6. Recombinant Protein Expression
2.7. Enzyme Properties of Recombinant Protein
2.8. Antifungal Activity of Recombinant Protein
3. Results
3.1. Identification and Sequence Analysis of PlTLPs
3.2. Expression Profiles of PlTLPs
3.3. Expression of Recombinant PlTLPs
3.4. Characterisation of Enzymatic Activity of Recombinant PlTLPs
3.5. Antifungal Activity of Recombinant PlTLPs
4. Discussion
5. Conclusions
Supplementary Materials
Author Contributions
Funding
Acknowledgments
Conflicts of Interest
References
- Kazan, K.; Lyons, R. Intervention of Phytohormone Pathways by Pathogen Effectors. Plant Cell 2014, 26, 2285–2309. [Google Scholar] [CrossRef] [Green Version]
- Bonello, P.; Gordon, T.R.; Herms, D.A.; Wood, D.L.; Erbilgin, N. Nature and ecological implications of pathogen-induced systemic resistance in conifers: A novel hypothesis. Physiol. Mol. Plant Pathol. 2006, 68, 95–104. [Google Scholar] [CrossRef]
- Cao, J.; Lv, Y.Q.; Hou, Z.R.; Li, X.; Ding, L.N. Expansion and evolution of thaumatin-like protein (TLP) gene family in six plants. Plant Growth Regul. 2016, 79, 299–307. [Google Scholar] [CrossRef]
- Hakim; Ullah, A.; Hussain, A.; Shaban, M.; Khan, A.H.; Alariqi, M.; Gul, S.; Jun, Z.; Lin, S.; Li, J.Y.; et al. Osmotin: A plant defense tool against biotic and abiotic stresses. Plant Physiol. Biochem. 2018, 123, 149–159. [Google Scholar] [CrossRef]
- Musidlak, O.; Nawrot, R.; Goździcka-Józefiak, A. Which Plant Proteins Are Involved in Antiviral Defense? Review on In Vivo and In Vitro Activities of Selected Plant Proteins against Viruses. Int. J. Mol. Sci. 2017, 18, 2300. [Google Scholar] [CrossRef] [Green Version]
- Zhang, M.; Xu, J.H.; Liu, G.; Yang, X.P. Antifungal properties of a thaumatin-like protein from watermelon. Acta. Physiol. Plant 2018, 40, 186. [Google Scholar] [CrossRef]
- Kovalchuk, A.; Keriö, S.; Oghenekaro, A.O.; Jaber, E.; Raffaello, T.; Asiegbu, F.O. Antimicrobial Defenses and Resistance in Forest Trees: Challenges and Perspectives in a Genomic Era. Annu. Rev. Phytopathol. 2013, 51, 221–244. [Google Scholar] [CrossRef]
- Petre, B.; Major, I.; Rouhier, N.; Duplessis, S. Genome-wide analysis of eukaryote thaumatin-like proteins (TLPs) with an emphasis on poplar. BMC Plant Biol. 2011, 11, 33. [Google Scholar] [CrossRef] [Green Version]
- Meng, F.L.; Wang, J.; Wang, X.; Li, Y.X.; Zhang, X.Y. Expression analysis of thaumatin-like proteins from Bursaphelenchus xylophilus and Pinus massoniana. Physiol. Mol. Plant Pathol. 2017, 100, 178–184. [Google Scholar] [CrossRef]
- Franco, S.D.F.; Baroni, R.M.; Carazzolle, M.F.; Teixeira, P.J.P.L.; Reis, O.; Pereira, G.A.G.; Mondego, J.M.C. Genomic analyses and expression evaluation of thaumatin-like gene family in the cacao fungal pathogen Moniliophthora perniciosa. Biochem. Biophys. Res. Commun. 2015, 466, 629–636. [Google Scholar] [CrossRef]
- Li, X.; Li, S.; Qiu, B.L.; Zhang, Y.P.; Cui, X.M.; Ge, F.; Liu, D.Q. Thaumatin-like protein genes of Panax notoginseng confers resistance to Alternaria panax. Physiol. Mol. Plant Pathol. 2020, 112, 101537. [Google Scholar] [CrossRef]
- Yan, X.X.; Qiao, H.B.; Zhang, X.M.; Guo, C.L.; Wang, M.N.; Wang, Y.J.; Wang, X.P. Analysis of the grape (Vitis vinifera L.) thaumatin-like protein (TLP) gene family and demonstration that TLP29 contributes to disease resistance. Sci. Rep. 2017, 7, 4269. [Google Scholar] [CrossRef] [PubMed] [Green Version]
- Smole, U.; Bublin, M.; Radauer, C.; Ebner, C.; Breiteneder, H. Mal d 2, the Thaumatin-Like Allergen from Apple, Is Highly Resistant to Gastrointestinal Digestion and Thermal Processing. Int. Arch. Allergy Immunol. 2008, 147, 289–298. [Google Scholar] [CrossRef]
- Guo, J.; Zhao, X.; Wang, H.L.; Yu, T.; Miao, Y.; Zheng, X.D. Expression of the LePR5 gene from cherry tomato fruit induced by Cryptococcus laurentii and the analysis of LePR5 protein antifungal activity. Postharvest Biol. Technol. 2016, 111, 337–344. [Google Scholar] [CrossRef]
- Rather, I.A.; Awasthi, P.; Mahajan, V.; Bedi, Y.S.; Vishwakarma, R.A.; Gandhi, S.G. Molecular cloning and functional characterization of an antifungal PR-5 protein from Ocimum basilicum. Gene 2015, 558, 143–151. [Google Scholar] [CrossRef] [PubMed]
- Hayashi, M.; Shiro, S.; Kanamori, H.; Mori-Hosokawa, S.; Sasaki-Yamagata, H.; Sayama, T.; Nishioka, M.; Takahashi, M.; Ishimoto, M.; Katayose, Y.; et al. A Thaumatin-Like Protein, Rj4, Controls Nodule Symbiotic Specificity in Soybean. Plant Cell Physiol. 2014, 55, 1679–1689. [Google Scholar] [CrossRef] [PubMed] [Green Version]
- Šņepste, I.; Šķipars, V.; Krivmane, B.; Brūna, L.; Ruņģis, D. Characterization of a Pinus sylvestris thaumatin-like protein gene and determination of antimicrobial activity of the in vitro expressed protein. Tree Genet. Genomes 2018, 14, 58. [Google Scholar] [CrossRef]
- Liu, J.; Han, D.P.; Shi, Y.W. Gene Cloning, Expression, and Antifungal Activities of Permatin from Naked Oat (Avena nuda). Probiotics Antimicrob. Proteins 2019, 11, 299–309. [Google Scholar] [CrossRef]
- Rout, E.; Nanda, S.; Joshi, R.K. Molecular characterization and heterologous expression of a pathogen induced PR5 gene from garlic (Allium sativum L.) conferring enhanced resistance to necrotrophic fungi. Eur. J. Plant Pathol. 2016, 144, 345–360. [Google Scholar] [CrossRef]
- Mahdavi, F.; Sariah, M.; Maziah, M. Expression of Rice Thaumatin-Like Protein Gene in Transgenic Banana Plants Enhances Resistance to Fusarium Wilt. Appl. Biochem. Biotechnol. 2012, 166, 1008–1019. [Google Scholar] [CrossRef]
- Munis, M.F.H.; Tu, L.; Deng, F.L.; Tan, J.F.; Xu, L.; Xu, S.C.; Long, L.; Zhang, X.L. A thaumatin-like protein gene involved in cotton fiber secondary cell wall development enhances resistance against Verticillium dahliae and other stresses in transgenic tobacco. Biochem. Biophys. Res. Commun. 2010, 393, 38–44. [Google Scholar] [CrossRef]
- Liu, J.J.; Zamani, A.; Ekramoddoullah, A.K.M. Expression profiling of a complex thaumatin-like protein family in western white pine. Planta 2010, 231, 637–651. [Google Scholar] [CrossRef]
- Sun, W.B.; Zhou, Y.; Movahedi, A.; Wei, H.; Zhuge, Q. Thaumatin-like protein(Pe-TLP)acts as a positive factor in transgenic poplars enhanced resistance to spots disease. Physiol. Mol. Plant Pathol. 2020, 112, 101512. [Google Scholar] [CrossRef]
- Muoki, R.C.; Paul, A.; Kaachra, A.; Kumar, S. Membrane localized thaumatin-like protein from tea (CsTLP) enhanced seed yield and the plant survival under drought stress in Arabidopsis thaliana. Plant Physiol. Biochem. 2021, 163, 36–44. [Google Scholar] [CrossRef] [PubMed]
- Li, Z.S.; Wang, X.Y.; Cui, Y.P.; Qiao, K.K.; Zhu, L.F.; Fan, S.L.; Ma, Q.F. Comprehensive Genome-Wide Analysis of Thaumatin-Like Gene Family in Four Cotton Species and Functional Identification of GhTLP19 Involved in Regulating Tolerance to Verticillium dahlia and Drought. Front. Plant Sci. 2020, 11, 575015. [Google Scholar] [CrossRef] [PubMed]
- Van der Maelen, E.; Rezaei, M.N.; Struyf, N.; Proost, P.; Verstrepen, K.J.; Courtin, C.M. Identification of a Wheat Thaumatin-like Protein That Inhibits Saccharomyces cerevisiae. J. Agric. Food Chem. 2019, 67, 10423–10431. [Google Scholar] [CrossRef]
- Wang, L.; Yang, L.; Zhang, J.; Dong, J.; Yu, J.; Zhou, J.; Zhuge, Q. Cloning and characterization of a thaumatin-like protein gene PeTLP in Populus deltoides × P. euramericana cv. ‘Nanlin895′. Acta. Physiol. Plant 2013, 35, 2985–2998. [Google Scholar] [CrossRef]
- Osmond, R.I.W.; Hrmova, M.; Fontaine, F.; Imberty, A.; Fincher, G.B. Binding interactions between barley thaumatin-like proteins and (1,3)-β-D-glucans. Eur. J. Biochem. 2001, 268, 4190–4199. [Google Scholar] [CrossRef]
- Menu-Bouaouiche, L.; Vriet, C.; Peumans, W.J.; Barre, A.; Van Damme, E.J.M.; Rougé, P. A molecular basis for the endo-β1,3-glucanase activity of the thaumatin-like proteins from edible fruits. Biochimie 2003, 85, 123–131. [Google Scholar] [CrossRef]
- Theis, T.; Stahl, U. Antifungal proteins: Targets, mechanisms and prospective applications. Cell. Mol. Life Sci. 2004, 61, 437–455. [Google Scholar] [CrossRef]
- Grenier, J.; Potvin, C.; Trudel, J.; Asselin, A. Some thaumatin-like proteins hydrolyse polymeric β-1,3-glucans. Plant J. 1999, 19, 473–480. [Google Scholar] [CrossRef]
- Aghazadeh, R.; Zamani, M.; Motallebi, M.; Moradyar, M. Agrobacterium-Mediated Transformation of the Oryza sativa Thaumatin-Like Protein to Canola (R Line Hyola308) for Enhancing Resistance to Sclerotinia sclerotiorum. Iran. J. Biotechnol. 2017, 15, 201–207. [Google Scholar] [CrossRef] [Green Version]
- de Freitas, C.D.T.; Lopes, J.L.D.S.; Beltramini, L.M.; de Oliveira, R.S.B.; Oliveira, J.T.A.; Ramos, M.V. Osmotin from Calotropis procera latex: New insights into structure and antifungal properties. Biochim. Biophys. Acta (BBA)—Biomembr. 2011, 1808, 2501–2507. [Google Scholar] [CrossRef] [PubMed]
- Tanney, J.B.; Seifert, K.A. Lophodermium resinosum sp. nov. from red pine (Pinus resinosa) in Eastern Canada. Botany 2017, 95, 773–784. [Google Scholar] [CrossRef] [Green Version]
- Korkama-Rajala, T.; Müller, M.M.; Pennanen, T. Decomposition and Fungi of Needle Litter from Slow- and Fast-growing Norway Spruce (Picea abies) Clones. Microb. Ecol. 2008, 56, 76–89. [Google Scholar] [CrossRef]
- Liu, Y.F.; Liu, L.J.; Yang, S.; Zeng, Q.; He, Z.R.; Liu, Y.G. Cloning, Characterization and Expression of the Phenylalanine Ammonia-Lyase Gene (PaPAL) from Spruce Picea asperata. Forests 2019, 10, 613. [Google Scholar] [CrossRef] [Green Version]
- Tamura, K.; Stecher, G.; Peterson, D.; Filipski, A.; Kumar, S. MEGA6: Molecular evolutionary genetics analysis version 6.0. Mol. Biol. Evol. 2013, 30, 2725–2729. [Google Scholar] [CrossRef] [PubMed] [Green Version]
- Livak, K.J.; Schmittgen, T.D. Analysis of relative gene expression data using real-time quantitative PCR and the 2−ΔΔCT method. Methods 2001, 25, 402–408. [Google Scholar] [CrossRef]
- Leone, P.; Menu-Bouaouiche, L.; Peumans, W.J.; Payan, F.; Barre, A.; Roussel, A.; Van Damme, E.J.M.; Rougé, P. Resolution of the structure of the allergenic and antifungal banana fruit thaumatin-like protein at 1.7-Å. Biochimie 2006, 88, 45–52. [Google Scholar] [CrossRef]
- Monteiro, S.; Barakat, M.; Piçarra-Pereira, M.A.; Teixeira, A.R.; Ferreira, R.B. Osmotin and Thaumatin from Grape: A Putative General Defense Mechanism Against Pathogenic Fungi. Phytopathology 2003, 93, 1505–1512. [Google Scholar] [CrossRef] [Green Version]
- Liu, M.; Zhang, D.; Xing, Y.; Guo, S. Cloning and expression of three thaumatin-like protein genes from Polyporus umbellatus. Acta Pharm. Sin. B 2017, 7, 373–380. [Google Scholar] [CrossRef]
- Liu, J.J.; Sturrock, R.; Ekramoddoullah, A.K.M. The superfamily of thaumatin-like proteins: Its origin, evolution, and expression towards biological function. Plant Cell Rep. 2010, 29, 419–436. [Google Scholar] [CrossRef]
- Wang, X.; Tang, C.; Deng, L.; Cai, G.; Liu, X.; Liu, B.; Han, Q.; Buchenauer, H.; Wei, G.; Han, D.; et al. Characterization of a pathogenesis-related thaumatin-like protein gene TaPR5 from wheat induced by stripe rust fungus. Physiol. Plant 2010, 139, 27–38. [Google Scholar] [CrossRef]
- O’Leary, S.J.B.; Poulis, B.A.D.; von Aderkas, P. Identification of two thaumatin-like proteins (TLPs) in the pollination drop of hybrid yew that may play a role in pathogen defence during pollen collection. Tree Physiol. 2007, 27, 1649–1659. [Google Scholar] [CrossRef] [Green Version]
- Fils-Lycaon, B.R.; Wiersma, P.A.; Eastwell, K.C.; Sautiere, P. A Cherry Protein and Its Gene, Abundantly Expressed in Ripening Fruit, Have Been Identified as Thaumatin-Like. Plant Physiol. 1996, 111, 269–273. [Google Scholar] [CrossRef] [Green Version]
- Kim, Y.S.; Park, J.Y.; Kim, K.S.; Ko, M.K.; Cheong, S.J.; Oh, B. A thaumatin-like gene in nonclimacteric pepper fruits used as molecular marker in probing disease resistance, ripening, and sugar accumulation. Plant Mol. Biol. 2002, 49, 125–135. [Google Scholar] [CrossRef]
- Esposito, D.; Chatterjee, D.K. Enhancement of soluble protein expression through the use of fusion tags. Curr. Opin. Biotechnol. 2006, 17, 353–358. [Google Scholar] [CrossRef]
- Urban, A.; Ansmant, I.; Motorin, Y. Optimisation of expression and purification of the recombinant Yol066 (Rib2) protein from Saccharomyces cerevisiae. J. Chromatogr. B 2003, 786, 187–195. [Google Scholar] [CrossRef]
- Wawra, S.; Fesel, P.; Widmer, H.; Timm, M.; Seibel, J.; Leson, L.; Kesseler, L.; Nostadt, R.; Hilbert, M.; Langen, G. The fungal-specific β-glucan-binding lectin FGB1 alters cell-wall composition and suppresses glucan-triggered immunity in plants. Nat. Commun. 2016, 7, 13188. [Google Scholar] [CrossRef]
- Barre, A.; Peumans, W.J.; Menu-Bouaouiche, L.; Van Damme, E.J.M.; May, G.D.; Fernandez Herrera, A.; Van Leuven, F.; Rougé, P. Purification and structural analysis of an abundant thaumatin-like protein from ripe banana fruit. Planta 2000, 211, 791–799. [Google Scholar] [CrossRef]
- Palacín, A.; Tordesillas, L.; Gamboa, P.; Sanchez-Monge, R.; Cuesta-Herranz, J.; Sanz, M.L.; Barber, D.; Salcedo, G.; Díaz-Perales, A. Characterization of peach thaumatin-like proteins and their identification as major peach allergens. Clin. Exp. Allergy 2010, 40, 1422–1430. [Google Scholar] [CrossRef] [PubMed]
- Misra, R.C.; Sandeep; Kamthan, M.; Kumar, S.; Ghosh, S. A thaumatin-like protein of Ocimum basilicum confers tolerance to fungal pathogen and abiotic stress in transgenic Arabidopsis. Sci. Rep. 2016, 6, 25340. [Google Scholar] [CrossRef]
- Singh, N.K.; Kumar, K.R.R.; Kumar, D.; Shukla, P.; Kirti, P.B. Characterization of a Pathogen Induced Thaumatin-Like Protein Gene AdTLP from Arachis diogoi, a Wild Peanut. PLoS ONE 2013, 8, e83963. [Google Scholar]

| Gene Name | CDS Length (bp) | Amino Acids No. | MW (kDa) | pI |
|---|---|---|---|---|
| PlTLP1 | 705 | 234 | 24.869 | 8.83 |
| PlTLP2 | 747 | 248 | 26.775 | 8.52 |
| PlTLP3 | 705 | 234 | 24.684 | 4.57 |
| PlTLP4 | 969 | 322 | 33.450 | 4.86 |
Publisher’s Note: MDPI stays neutral with regard to jurisdictional claims in published maps and institutional affiliations. |
© 2021 by the authors. Licensee MDPI, Basel, Switzerland. This article is an open access article distributed under the terms and conditions of the Creative Commons Attribution (CC BY) license (https://creativecommons.org/licenses/by/4.0/).
Share and Cite
Liu, Y.; Liu, L.; Asiegbu, F.O.; Yang, C.; Han, S.; Yang, S.; Zeng, Q.; Liu, Y. Molecular Identification and Antifungal Properties of Four Thaumatin-like Proteins in Spruce (Picea likiangensis). Forests 2021, 12, 1268. https://doi.org/10.3390/f12091268
Liu Y, Liu L, Asiegbu FO, Yang C, Han S, Yang S, Zeng Q, Liu Y. Molecular Identification and Antifungal Properties of Four Thaumatin-like Proteins in Spruce (Picea likiangensis). Forests. 2021; 12(9):1268. https://doi.org/10.3390/f12091268
Chicago/Turabian StyleLiu, Yufeng, Lijuan Liu, Fred O. Asiegbu, Chunlin Yang, Shan Han, Shuai Yang, Qian Zeng, and Yinggao Liu. 2021. "Molecular Identification and Antifungal Properties of Four Thaumatin-like Proteins in Spruce (Picea likiangensis)" Forests 12, no. 9: 1268. https://doi.org/10.3390/f12091268
APA StyleLiu, Y., Liu, L., Asiegbu, F. O., Yang, C., Han, S., Yang, S., Zeng, Q., & Liu, Y. (2021). Molecular Identification and Antifungal Properties of Four Thaumatin-like Proteins in Spruce (Picea likiangensis). Forests, 12(9), 1268. https://doi.org/10.3390/f12091268

